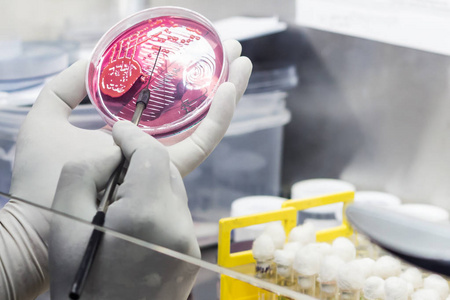
殖民地的微生物微生物实验室油烟机内的科学家接种环培养板细菌接种
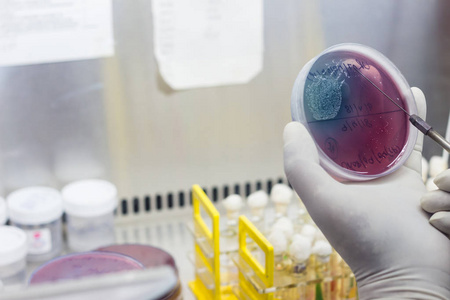
微生物实验室油烟机内的科学家接种循环培养板上的血琼脂接种照片

微生物接种

微生物实验室中科学家实验室技术员接种环培养板细菌接种研究
图片尺寸700x467
微生物学家接种营养琼脂的手照片
图片尺寸449x300
微生物接种方法有哪几种?
图片尺寸600x354
微生物接种片段
图片尺寸1528x1200
你好,微生物
图片尺寸1440x1080
医学微生物学实验2细菌接种法
图片尺寸920x690
微生物检测中常用的细菌接种方法汇总(三)! - 知乎
图片尺寸6000x4000
微生物接种回路在灵灯火焰中加热微生物实验室灭菌消毒殖民地的真菌
图片尺寸450x300
微生物学家手培养培养皿白衣接种循环,在高压釜旁边
图片尺寸700x467
微生物技术细菌接种在试管琼脂培养基上使用接种环由科学家实验室技术
图片尺寸450x300
殖民地的微生物微生物实验室油烟机内的科学家接种环培养板细菌接种
图片尺寸450x300
微生物三点接种法了解一下!
图片尺寸640x476
微生物学家手培养培养皿白衣接种循环,在高压釜旁边
图片尺寸700x467
微生物的无菌接种——液体摇瓶的接种
图片尺寸1280x720
殖民地的微生物微生物实验室中科学家实验室技术员接种环培养板细菌
图片尺寸450x300
中心医院病原微生物学实验室,工作人员在生物安全柜中对细菌进行接种
图片尺寸431x600
细菌接种在试管琼脂培养基上使用接种环由科学家实验室技术员在微生物
图片尺寸450x300
食品微生物检验规范
图片尺寸574x458
微生物三点接种法了解一下
图片尺寸740x360
微生物实验室油烟机内的科学家接种循环培养板上的血琼脂接种照片
图片尺寸450x300